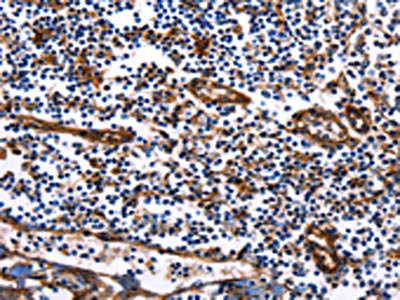

DUSP6 Antibody
-
中文名稱:DUSP6兔多克隆抗體
-
貨號:CSB-PA625538
-
規格:¥1100
-
圖片:
-
The image on the left is immunohistochemistry of paraffin-embedded Human ovarian cancer tissue using CSB-PA625538(DUSP6 Antibody) at dilution 1/25, on the right is treated with fusion protein. (Original magnification: ×200)
-
The image on the left is immunohistochemistry of paraffin-embedded Human tonsil tissue using CSB-PA625538(DUSP6 Antibody) at dilution 1/25, on the right is treated with fusion protein. (Original magnification: ×200)
-
Gel: 10%SDS-PAGE, Lysate: 30 μg, Lane 1-2: Jurkat cells, human fetal kidney tissue, Primary antibody: CSB-PA625538(DUSP6 Antibody) at dilution 1/450, Secondary antibody: Goat anti rabbit IgG at 1/8000 dilution, Exposure time: 1 minute
-
-
其他:
產品詳情
-
Uniprot No.:
-
基因名:
-
別名:Dual specificity phosphatase 6 antibody; Dual specificity phosphatase 6 isoform a antibody; Dual specificity protein phosphatase 6 antibody; Dual specificity protein phosphatase PYST1 antibody; DUS6_HUMAN antibody; DUSP 6 antibody; DUSP 6a antibody; Dusp6 antibody; DUSP6a antibody; HH19 antibody; MAP kinase phosphatase 3 antibody; Mitogen activated protein kinase phosphatase 3 antibody; Mitogen-activated protein kinase phosphatase 3 antibody; MKP 3 antibody; MKP-3 antibody; MKP3 antibody; PYST 1 antibody; PYST1 antibody; Serine/threonine specific protein phosphatase antibody
-
宿主:Rabbit
-
反應種屬:Human,Mouse,Rat
-
免疫原:Fusion protein of Human DUSP6
-
免疫原種屬:Homo sapiens (Human)
-
標記方式:Non-conjugated
-
抗體亞型:IgG
-
純化方式:Antigen affinity purification
-
濃度:It differs from different batches. Please contact us to confirm it.
-
保存緩沖液:-20°C, pH7.4 PBS, 0.05% NaN3, 40% Glycerol
-
產品提供形式:Liquid
-
應用范圍:ELISA,WB,IHC
-
推薦稀釋比:
Application Recommended Dilution ELISA 1:1000-1:5000 WB 1:500-1:2000 IHC 1:25-1:100 -
Protocols:
-
儲存條件:Upon receipt, store at -20°C or -80°C. Avoid repeated freeze.
-
貨期:Basically, we can dispatch the products out in 1-3 working days after receiving your orders. Delivery time maybe differs from different purchasing way or location, please kindly consult your local distributors for specific delivery time.
-
用途:For Research Use Only. Not for use in diagnostic or therapeutic procedures.
相關產品
靶點詳情
-
功能:Inactivates MAP kinases. Has a specificity for the ERK family. Plays an important role in alleviating chronic postoperative pain. Necessary for the normal dephosphorylation of the long-lasting phosphorylated forms of spinal MAPK1/3 and MAP kinase p38 induced by peripheral surgery, which drives the resolution of acute postoperative allodynia. Also important for dephosphorylation of MAPK1/3 in local wound tissue, which further contributes to resolution of acute pain. Promotes cell differentiation by regulating MAPK1/MAPK3 activity and regulating the expression of AP1 transcription factors.
-
基因功能參考文獻:
- Individuals are carrying DUSP6 rs2279574 AA and AC genotypes associated with an increased risk in developing lung squamous carcinoma in Han Chinese and with advanced NSCLC stages. PMID: 29578153
- DUSP6 expression in skeletal muscle was reduced by 43% just after exercise and remained below pre-exercise level after 2 h recovery. PMID: 28989118
- Data show that oxidative stress and MAP kinase phosphatase 3 (MKP3) inhibition play a critical role in procyanidin B2 3,3''-di-O-gallate (B2G2)-induced cell death in prostate cancer (PCa) cells through sustained activation of both ERK1/2 and AMPKalpha. PMID: 28876465
- High DUSP6 expression is associated with Lung Squamous Cell Carcinoma. PMID: 27613525
- Authors demonstrate the broad applicability of this recombination-based method and they proved its potential to identify new drug targets via the identification of the tumor suppressor DUSP6 as potential synthetic lethal target in melanoma cell lines with BRAF V600E mutations and high DUSP6 expression. PMID: 28423600
- PICSAR has a role in promoting cSCC progression via activation of extracellular signal-regulated kinase 1/2 signaling pathway by downregulating DUSP6 expression PMID: 27049681
- DUSP6 rs2279574 SNPs was not associated with chemoradiotherapy response, whereas tumor regression, weight loss, clinical stage, and cigarette smoking were independent prognostic predictors for these Chinese patients with non-small cell lung cancer. PMID: 28231233
- DNA samples from each patient were genotyped for DUSP6 and TOP2A SNPs PMID: 27156317
- Suppression of the FOXA1/DUSP6 signaling pathway may contribute to the development of Hirschsprung disease. PMID: 26097584
- These observations led us to conclude that increased TSH signaling overcomes OIS and is essential for B-RafV600E-induced papillary thyroid carcinogenesis. PMID: 25499223
- Dusp6 expression was higher in progestin-sensitive atypical endometrial hyperplasia groups compared with progestin-resistant groups. After treatment, Dusp6 expression was upregulated in progestin-sensitive groups, but not in progestin-resistant groups. PMID: 25451692
- Our results suggest that DUSP6 gene expression in tumour samples may be a prognostic marker in NSCLC PMID: 25344212
- DUSP6 downregulated the expression of matrix metallopeptidase 3. PMID: 25241655
- These results therefore indicate that p53-mediated up-regulation of MKP-3 contributes to the establishment of the senescent cellular phenotype through dephosphorylating ERK1/2 PMID: 25414256
- Downregulation of Dusp6, Sprouty4, and Sef--negative modulators of FGF2/ERK1/2 signaling--was present in eutopic endometria of adenomyosis, which may play critical roles in the development of adenomyosis. PMID: 24681741
- Higher expression of DUSP6 in tumor tissue, than in peritumor tissue, is associated with the recurrence after curative resection of HCC, and the relative tumor DUSP6 expression has good power to predict the recurrence of HCC. PMID: 24709168
- suggest an important role for DeltaNp63alpha in preventing cancer metastasis by inhibition of Erk2 signaling via MKP3 subscribing PMID: 23246965
- Dusp6 overexpression is involved in the pathogenesis and development of human endometrial adenocarcinoma. PMID: 23419500
- Increased DUSP6 expression is associated with papillary thyroid carcinoma. PMID: 24222120
- Depletion of DUSP6 reduced the viability of cancer cell lines and increased the cytotoxicity of EGFR and other targeted inhibitors, and cytotoxic agents. PMID: 23839489
- missense mutation, c.545C>T (p.Ser182Phe), in the DUSP6 gene may be genetically linked to the Class III malocclusion PMID: 23965468
- DUSP6 is overexpressed in papillary and poorly differentiated thyroid carcinoma and contributes to neoplastic properties of thyroid cancer cells. PMID: 23132790
- The results provide insights on the modulatory role of p53 in the survival pathway by up-regulating DUSP6. PMID: 23108049
- study reports that naive CD4 T cells from elderly individuals have reduced signaling capacity of the ERK pathway; the underlying mechanism is an age-related decline in miR-181a expression and associated rise in levels of DUSP6 expression PMID: 23023500
- ischemia/reperfusion inhibited eNOS expression by inactivation of ERK1/2, leading to decreased NO formation through a MKP-3-dependent mechanism in endothelial cells PMID: 22848708
- DUSP6 plays an important role in the pathogenesis of bipolar disorder, particularly in women. PMID: 22155192
- MESP2, HES7 and DUSP6 genes may not be involved in the etiopathogenesis of sporadic and non-syndromic CS in Chinese Han population. PMID: 22744456
- A link between DUSP6 expression and high-risk features of papillary thyroid carcinoma suggested that DUSP6 is an important independent factor affecting the signaling pathways in established papillary thyroid carcinoma. PMID: 22535643
- DUSP6 is important in melanoma and it plays a different role in the distinct subtype of mouse melanoma compared with that in classic human melanoma. PMID: 22171919
- caspase-3 cleavage of MKP3 down-regulates MKP3 full length and renders active MKP3 fragments, which may participate in novel regulatory pathways controlling the subcellular localization and activation of ERK1/2 during apoptosis. PMID: 22504224
- Studies identified a single gene DUSP6, whose expression was associated with sensitivity to GSK1120212. PMID: 22169769
- Studies indicate that ERKs stimulate their own dephosphorylation by directly binding to phosphatases, such as MKP-3, and activating them. PMID: 22028468
- Loss of DUSP6 is associated with esophageal squamous cell carcinoma and nasopharyngeal carcinoma. PMID: 21387288
- DUSP6 plays an important role in cancer resistance in different subtypes of non-small cell lung carcinoma. PMID: 21680106
- upregulation of DUSP6 exerts a tumor-promoting role in human glioblastomas exacerbating the malignant phenotype. PMID: 21499306
- MKP3 not only controls the activities of ERK2 and p38alpha but also mediates cross-talk between these two MAPK pathways. PMID: 21454500
- This study shows that post-transcriptional regulation is a key process in the control of DUSP6 expression. PMID: 20665674
- DUSP6 methylation is a rare event in endometrial cancer. Silencing of the DUSP6 phosphatase is unlikely to contribute to constitutive activation of the ERK kinase cascade in endometrial cancer. PMID: 20638106
- Dual specificity phosphatase 6 (DUSP6) is an ETS-regulated negative feedback mediator of oncogenic ERK signaling in lung cancer cells. PMID: 20097731
- Angiotensin II-induced upregulation of MAP kinase phosphatase-3 mRNA levels mediates endothelial cell apoptosis PMID: 11998972
- Results show that DUSP6 exerts apparent tumor-suppressive effects in vitro and suggest that DUSP6 is a strong candidate tumor suppressor gene at 12q22 locus. PMID: 12759238
- Constitutive induction of p-Erk1/2 accompanied by reduced activities of protein phosphatases 1 and 2A and MKP3 due to reactive oxygen species during cellular senescence. PMID: 12840032
- Study gives first direct evidence that the N-terminal domain of MKP3 mediates intramolecular dephosphorylation between the monomeric form of phosphorylated extracellular signal-regulated kinase and a monomer of MKP3. PMID: 14690430
- cytoplasmic localization of MKP3 is mediated by a chromosome region maintenance-1 (CRM1)-dependent nuclear export pathway; the ability of MKP3 to cause the cytoplasmic retention of ERK2 requires both a functional kinase interaction motif and NES PMID: 15269220
- Hypermethylation with modification of histone deacetylation play an important role in transcriptional suppression of DUSP6 in human pancreatic cancer PMID: 15824892
- Results suggest that the abrogation of DUSP6 is associated exclusively with progression from pancreatic intraepithelial neoplasia to the invasive ductal carcinoma. PMID: 15832194
- Results demonstrate that in the Korean population DUSP6 may contribute to the etiology of bipolar disorder, but not schizophrenia. PMID: 16491131
- Nuclear matrix proteins such as mutant Pyst1 and nucleophosmin 1 were downregulated, whereas eIF6 and beta-tubulin were upregulated during cell differentiation in hepatocarcinoma cells. PMID: 17569113
- even upon over-expression DUSP6 fails to inactivate ERK5, confirming that it is indeed an ERK1/2-specific DUSP PMID: 18280112
- MKP3 can act to enhance DAT function and is a phosphatase involved in regulating dynamin-dependent endocysis PMID: 18434601
顯示更多
收起更多
-
相關疾病:Hypogonadotropic hypogonadism 19 with or without anosmia (HH19)
-
亞細胞定位:Cytoplasm.
-
蛋白家族:Protein-tyrosine phosphatase family, Non-receptor class dual specificity subfamily
-
組織特異性:Expressed in keratinocytes (at protein level).
-
數據庫鏈接:
Most popular with customers
-
-
YWHAB Recombinant Monoclonal Antibody
Applications: ELISA, WB, IHC, IF, FC
Species Reactivity: Human, Mouse, Rat
-
Phospho-YAP1 (S127) Recombinant Monoclonal Antibody
Applications: ELISA, WB, IHC
Species Reactivity: Human
-
-
-
-
-